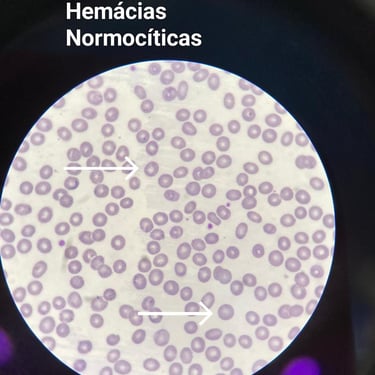
Normocitose

Parcerias institucionais estratégicas com empresas que vivem o universo das Análises Clínicas. Veja nosso portfólio institucional de divulgação.

HCM, VCM, CHCM e RDW: Entenda os índices hematimétricos no hemograma
Descubra como VCM, HCM, CHCM e RDW ajudam a entender as anemias e outras alterações do sangue. Uma leitura completa para estudantes, profissionais de saúde e leigos curiosos sobre os bastidores do hemograma.
HEMATOLOGIA
Ariéu Azevedo Moraes
4/16/20256 min ler


Índices Hematimétricos: O que o tamanho, a cor e a distribuição das hemácias contam sobre sua saúde?
Os índices hematimétricos são indicadores automáticos que revelam:
VCM, o tamanho médio das hemácias;
HCM, a quantidade de hemoglobina por célula;
CHCM, a concentração de hemoglobina nas hemácias;
RDW, a variação de tamanho entre as hemácias.
Juntos, formam uma poderosa ferramenta para diagnosticar anemias, acompanhar tratamentos e levantar suspeitas de distúrbios genéticos.
Quem nunca se deparou com um hemograma repleto de siglas e números e ficou sem saber por onde começar? O exame mais solicitado da medicina tem muito a dizer — e os índices hematimétricos estão entre as informações mais subestimadas. Esses parâmetros, calculados de forma automatizada, descrevem características fundamentais das hemácias, como tamanho, pigmentação e regularidade.
Mais do que simples números, os índices hematimétricos são verdadeiros contadores de histórias do organismo. Eles revelam deficiências nutricionais, alterações genéticas, respostas a tratamentos e condições crônicas muitas vezes silenciosas. Neste artigo, vamos mergulhar nesses indicadores com profundidade, mantendo uma linguagem acessível e foco na aplicação clínica.
O que são índices hematimétricos?
Esses índices fazem parte do hemograma automatizado. Eles são calculados a partir de três dados básicos: a contagem de hemácias, a dosagem da hemoglobina e o valor do hematócrito. A partir daí, os analisadores hematológicos geram valores que ajudam a entender não apenas a quantidade, mas a qualidade das células vermelhas.
É como se o hemograma ganhasse uma lente de aumento, permitindo enxergar nuances invisíveis à simples contagem celular.
Entenda os Índices Hematimétricos com Clareza — Comece pelo Capítulo Gratuito!
Ainda confunde VCM, HCM, CHCM e RDW?
Baixe gratuitamente o primeiro capítulo do nosso e-book e descubra como interpretar esses índices com segurança, utilizando gráficos, exemplos práticos e linguagem acessível.
👉 Clique aqui para baixar o capítulo grátis em PDF
Se gostar do conteúdo, você pode adquirir a versão completa com estudos de caso, tabelas comparativas e um guia visual para dominar a diferenciação das anemias. Clique aqui.
Conheça os principais índices
Volume Corpuscular Médio (VCM)
O VCM indica o tamanho médio das hemácias. Quando esse valor está abaixo do normal, é provável que o paciente tenha uma anemia microcítica, como a causada por deficiência de ferro. Se o VCM estiver dentro da faixa esperada, fala-se em anemia normocítica, que pode aparecer em casos de doenças crônicas ou perdas sanguíneas agudas. Já valores acima do padrão sugerem uma anemia macrocítica, frequentemente relacionada à falta de vitamina B12 ou ácido fólico.
Um exemplo prático: um paciente com fadiga persistente e VCM elevado pode estar diante de uma deficiência vitamínica, mesmo que os níveis de hemoglobina estejam limítrofes.
Hemoglobina Corpuscular Média (HCM)
O HCM quantifica a quantidade absoluta de hemoglobina presente em cada hemácia. Baixos níveis indicam que as células estão hipocrômicas, ou seja, com pouca coloração — o que geralmente acompanha anemias ferroprivas. Já valores normais ou elevados apontam para hemácias bem pigmentadas, o que nem sempre significa normalidade, pois a distribuição da hemoglobina ainda precisa ser avaliada.
É aí que entra o próximo índice.
Concentração de Hemoglobina Corpuscular Média (CHCM)
O CHCM mostra o quanto de hemoglobina está concentrada dentro de cada hemácia. Se estiver reduzido, confirma a presença de hipocromia — ou seja, células menos eficientes na oxigenação. Essa alteração é muito comum em casos de anemia por deficiência de ferro.
Por outro lado, quando o CHCM está acima do normal, pode indicar esferocitose hereditária, uma condição genética em que as hemácias assumem formato esférico, aumentando a concentração de hemoglobina no interior celular. Desidratação intensa ou artefatos laboratoriais também podem levar ao aumento desse índice.
Amplitude de Distribuição das Hemácias (RDW)
O RDW mede a variação de tamanho entre as hemácias, fenômeno conhecido como anisocitose. Quanto maior essa variação, maior o valor do RDW.
Esse índice é especialmente interessante por indicar mudanças precoces no perfil hematológico. Um RDW aumentado, mesmo com VCM normal, pode ser um dos primeiros sinais de uma deficiência nutricional, antes que a anemia se instale completamente.
Em outro contexto, um RDW normal em meio a outros índices alterados pode apontar para anemias hereditárias, como a talassemia menor, que apresenta pouca variação no tamanho das hemácias.
A interpretação clínica dos índices
O verdadeiro valor dos índices hematimétricos está na correlação entre eles. Raramente um parâmetro isolado é suficiente para chegar a um diagnóstico confiável. É no cruzamento dos dados que o raciocínio clínico floresce.
Imagine um paciente com VCM, HCM e CHCM todos abaixo do normal, mas RDW elevado. A combinação é típica de anemia ferropriva. Já um paciente com VCM elevado, CHCM normal e RDW aumentado pode estar enfrentando uma anemia megaloblástica, comum em casos de carência de vitamina B12.
Quando os quatro índices estão normais, mas há sintomas clínicos evidentes, considera-se anemia normocítica normocrômica, frequentemente relacionada a processos crônicos ou inflamatórios.
Para além das anemias
Os índices hematimétricos não servem apenas para diagnosticar anemia. Eles são ferramentas poderosas para:
Acompanhar a eficácia de tratamentos com ferro, vitamina B12 ou ácido fólico;
Avaliar a resposta da medula óssea após quadros de aplasia ou quimioterapia;
Diferenciar doenças carenciais de distúrbios genéticos, como talassemias e esferocitoses;
Monitorar pacientes com doenças crônicas, como insuficiência renal ou doenças inflamatórias intestinais.
O contexto clínico faz toda a diferença
Dois pacientes com os mesmos índices hematimétricos podem ter desfechos clínicos completamente diferentes. Uma gestante com CHCM reduzido deve ser avaliada com cuidado, pois há maior risco de complicações perinatais. Já um idoso assintomático com RDW levemente aumentado pode simplesmente estar diante de uma variação fisiológica da idade.
Por isso, ao analisar esses números, sempre considere:
Idade e sexo do paciente;
Presença ou ausência de sintomas;
Histórico nutricional e uso de medicamentos;
Altitude do local onde vive;
Situações específicas como gestação ou internações recentes.
O que pode interferir nos resultados?
Algumas situações podem alterar os índices hematimétricos, sem que haja, de fato, uma doença instalada. Entre elas, destacam-se:
Gravidez, especialmente no terceiro trimestre;
Idade avançada, com produção medular naturalmente reduzida;
Desidratação, que pode concentrar o sangue;
Uso de suplementos de ferro ou vitaminas, que modifica a produção das hemácias;
Coleta e processamento inadequados da amostra, resultando em artefatos laboratoriais.
Saber identificar essas interferências é fundamental para evitar erros de diagnóstico e reduzir o retrabalho no laboratório.
A visão biomédica e laboratorial
Para o profissional das análises clínicas, especialmente o biomédico, dominar a leitura dos índices hematimétricos é mais do que uma habilidade: é uma necessidade técnica e ética. Esses números oferecem indícios silenciosos, que só ganham voz quando interpretados com contexto e conhecimento.
Como resume o biomédico Ariéu Azevedo Moraes:
“Os índices hematimétricos são bússolas silenciosas no hemograma. Quem sabe lê-los com atenção, evita diagnósticos apressados.”
Finalizamos assim:
O hemograma vai muito além de números absolutos de hemoglobina. Quando olhamos com atenção para VCM, HCM, CHCM e RDW, descobrimos pistas preciosas sobre a saúde do paciente. Esses índices revelam como as hemácias estão se formando, maturando e se organizando no sangue — dados fundamentais para diagnosticar e acompanhar diversos quadros clínicos.
Dominar esse conteúdo não só enriquece a prática clínica, como aproxima os laboratórios da realidade do cuidado humanizado e proativo.
Calcule com mais precisão: conheça o PipetaCalc!
Precisa calcular VCM, HCM ou CHCM de forma rápida e segura, mesmo quando os dados não vêm completos no laudo?
Use o PipetaCalc — a ferramenta gratuita da Pipeta e Pesquisa que ajuda estudantes, biomédicos e técnicos a realizarem cálculos laboratoriais com segurança e agilidade.
Referências consultadas:

Continue com esses temas
Leia também: Por que alguns medicamentos alteram parâmetros bioquímicos e hematológicos e descubra quais cuidados tomar antes da coleta para garantir resultados confiáveis em: Exames laboratoriais e medicamentos: como o uso de remédios pode influenciar seus resultados.
E no Próximo artigo, Veja como as variações hormonais podem interferir nos resultados e aprenda a escolher o período ideal do ciclo para cada tipo de exame em: Como o ciclo menstrual afeta os exames laboratoriais — qual o melhor momento para coletar?
Escreva-se no Canal do YouTube
Deixe seu Comentário

Leitura rápida: principais pontos deste artigo
Para quem prefere uma visualização direta, os cards abaixo resumem os conceitos centrais abordados ao longo do texto, facilitando a revisão e a compreensão rápida dos temas discutidos.
Informações sobre saúde e Análises Clínicas para todos.
© 2025. Todos o Direitos Reservados - Pipeta e Pesquisa
BRASIL
TRÊS LAGOAS - MS
79600-000
Agendar Exames
Instrumental Laboratorial
Logística Laboratorial
"A Pipeta e Pesquisa opera através de suas unidades estratégicas: Pipeta Store, especializada em suprimentos; Pipeta Tech, focada em inovação laboratorial; e o Blog da Pipeta e Pesquisa, nosso hub de inteligência e educação."
